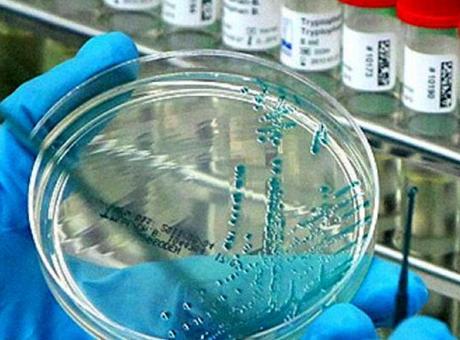
675a0443784fa370e2d278a4.jpg

Dünyadan Haberler
Moderator
AFP’nin haberine göre, yeni pandemi kuş gribi virüsü (H5N1) olabilir. “Science” (Bilim) dergisinde yayınlanan araştırmada da ABD’de inekleri etkileyen kuş gribi virüsünün, insanlar arasında daha etkili yayılmasının sadece bir mutasyon uzaklıkta olduğu bildirildi. ABD’de inekler arasında yayılıp insanları da enfekte eden kuş gribinin mutasyona uğrama belirtileri göstermesi üzerine sağlık uzmanları, H5N1’in pandemi tehdidine karşı alarma geçti. ABD’de kuş gribi teşhisi konulan 58 kişi arasındaki iki kişinin hayvanlarla temasları olmadığının belirlenmesi, endişeleri artırdı.
İlginizi Çekebilir
‘Çok şiddetli olur’
SAS Enstitüsü’nden epidemiyolog Meg Schaeffer, “Kuş gribi kapımızı çalıyor ve her an yeni bir pandemiye yol açabilir” düşüncesini destekleyen birkaç faktör bulunduğunu söyledi. Glasgow Üniversitesi’nden virolog Ed Hutchinson, bunun H5N1’in “bizim için daha tehlikeli hale gelmesine sadece basit bir adım” uzaklıkta olduğunu gösterdiğini söyledi. Hutchinson, “Kuş gribine yakalanan bir gencin genetik dizilimi, virüsün vücuttaki hücrelere daha etkili bağlanmak için evrimleşmeye başladığını gösteriyor. H5N1’in yayılmasına izin verilmesi, insanları daha kolay enfekte etme riskini artırıyor. İnsanlarda kuş gribi salgını olursa bu çok şiddetli olur, çünkü bizim gelişmiş bir bağışıklığımız yok” dedi.
Hem ölümcül hem bulaşıcı
Ölümcül kuş gribi türü H5N1 ilk 1996’da Çin’de ortaya çıktı ve son dört yılda yayıldı, hatta Antarktika gibi daha önce hiç dokunulmamış bölgelere ulaştı. Dünya Hayvan Sağlığı Örgütü, 2021’den bu yana 300 milyondan fazla kümes hayvanının itlaf edildiğini, 79 ülkede 315yabani kuş türünün ise öldüğünü söyledi. Enfekte kuşları yiyen memelilerde, örneğin foklarda da toplu ölümler gerçekleşti. Dünya Sağlık Örgütü’ne göre 2003’ten beri kaydedilen 904 adet H5N1 insan vakasının yarısı ölümcül oldu.
Çiğ süt çok riskli
Pandemi riski nedeniyle ABD Tarım Bakanlığı, çiğ sütlerde kuş gribi testi yapılmasını zorunlu kıldı. Pastörize edilmemiş sütün, H5N1’in bulaşması açısından büyük risk olduğu biliniyor. Ancak kaygı uyandıran konu, ABD Başkanı seçilen Trump’ın Sağlık Bakanlığı için aday gösterdiği Robert F. Kennedy’nin aşı karşıtı ve çiğ süt hayranı olması.
Sıtma kaynaklı ölümlerde artış
Dünya Sağlık Örgütü’ne göre, sıtma vakalarıartarken 2023’te 597 bin kişi bu hastalıktan öldü. Yetkililer, ilaçlara direnç, iklim ve insani felaketler gibi biyolojik tehditlerin kontrolü engellediğini bildirdi. Dünya genelinde geçen yıl 263 milyon sıtma vakası görüldü, bu bir önceki yıla göre 11 milyon fazla, vakaların yüzde 94’ü Afrika’daydı.
